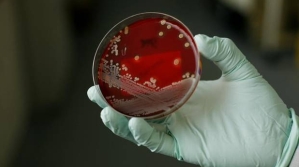
6076134

The spread of deadly, antibiotic resistant superbugs is already happening right under our noses, according to the World Health Organization (WHO), and the problem is going to get worse if things don't change.
According to a report released wednesday by the WHO, Antibiotic resistance has the potential to affect anyone, of any age, in any country,and It is now a major threat to public health and "the implications will be devastating".
"We have a big problem now, and all of the trends indicate the problem is going to get bigger," said Keiji Fukuda, the WHO's assistant director-general for health security.
The new report is a global assessment on antibiotic resistance, with data from 114 countries. In the findings, The WHO let the world know superbugs that are now able to evade even the hardest-hitting antibiotics - a class of drugs called carbapenems - have now been reported in every region of the world.
"The world is headed for a post-antibiotic era, in which common infections and minor injuries which have been treatable for decades can once again kill," Fukuda said.
Drug resistance is driven by the misuse and overuse of antibiotics, which encourages bacteria to develop new ways of overcoming them.
Consider the disease gonorrhoea, a dangerous sexually-transmitted sickness that infects more than a million people across the world every day. According the the report, antibiotic treatments are becoming more and more ineffective to treat the disease. Austria, Australia, Britain, Canada, France, Japan, Norway, South Africa, Slovenia and Sweden, all now report having patients with gonorrhoea that is totally untreatable.
"Unless we take significant actions to improve efforts to prevent infections and also change how we produce, prescribe and use antibiotics, the world will lose more and more of these global public health goods and the implications will be devastating," Fukuda continued, in the WHO statement.
The first thing people can do help prevent the spread of superbugs is not to misuse, or overuse antibiotics. The WHO also recommends that people take steps to prevent infections from happening in the first place-through better hygiene, gaining access to clean water, and improving infection control in health-care facilities. They also recommend vaccination to reduce the need for antibiotics. WHO is also calling attention to the need to develop new diagnostics, antibiotics and other tools to allow healthcare professionals to stay ahead of emerging resistance.
Only a handful of new antibiotics have been developed and brought to market in the past few decades, though. It's a constant struggle as researches try and develop new antibiotics as the bugs work to overcome the antibiotic.
One of the best known superbugs, MRSA, is estimated to kill around 19,000 people every year in the United States, alone. That is far more than HIV or AIDS.
The WHO hopes that releasing the report will kickstart global awareness of the problem and strategies will be adopted to overcome the crisis. This will involve the development of tools and standards and improved collaboration around the world to track drug resistance, measure its health and economic impacts, and design targeted solutions, according to the release.
The report states that the data only studies certain antibiotic resistant bugs, and that the problem may be even bigger than is currently believed.
The WHO said in some countries, because of resistance, carbapenems now do not work in more than half of people with common hospital-acquired infections caused by a bacteria called K. pneumoniae, such as pneumonia, blood infections, and infections in newborn babies and intensive-care patients.
Resistance to one of the most widely used antibiotics for urinary tract infections caused by E. coli - medicines called fluoroquinolones - is also very widespread, the WHO said.
In the 1980s, when these drugs were first introduced, resistance was virtually zero, according to the WHO report. But now there are countries in many parts of the world where the drugs are ineffective in more than half of patients.




